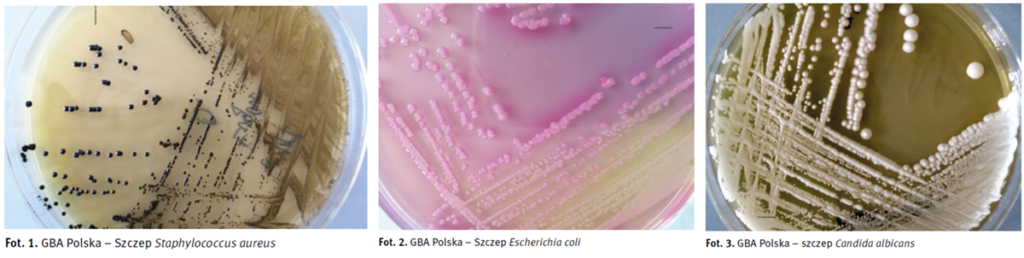
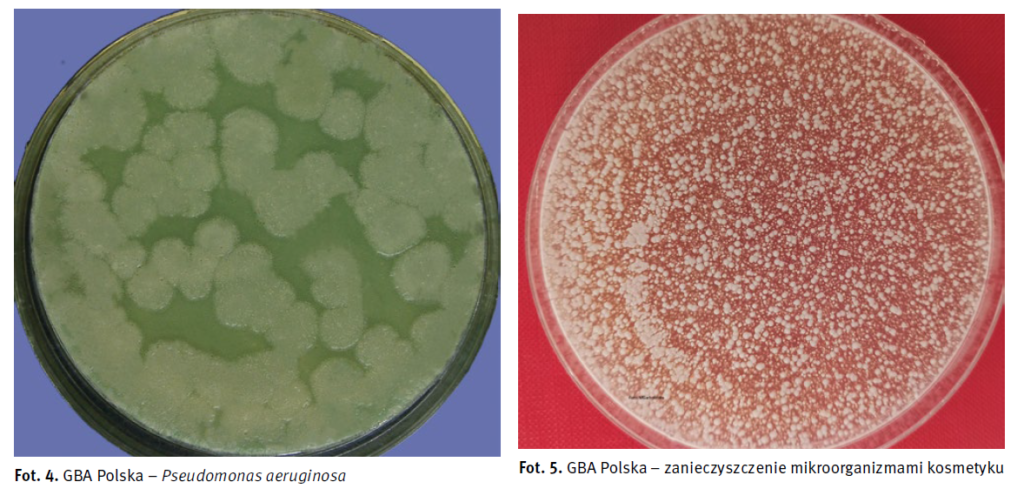
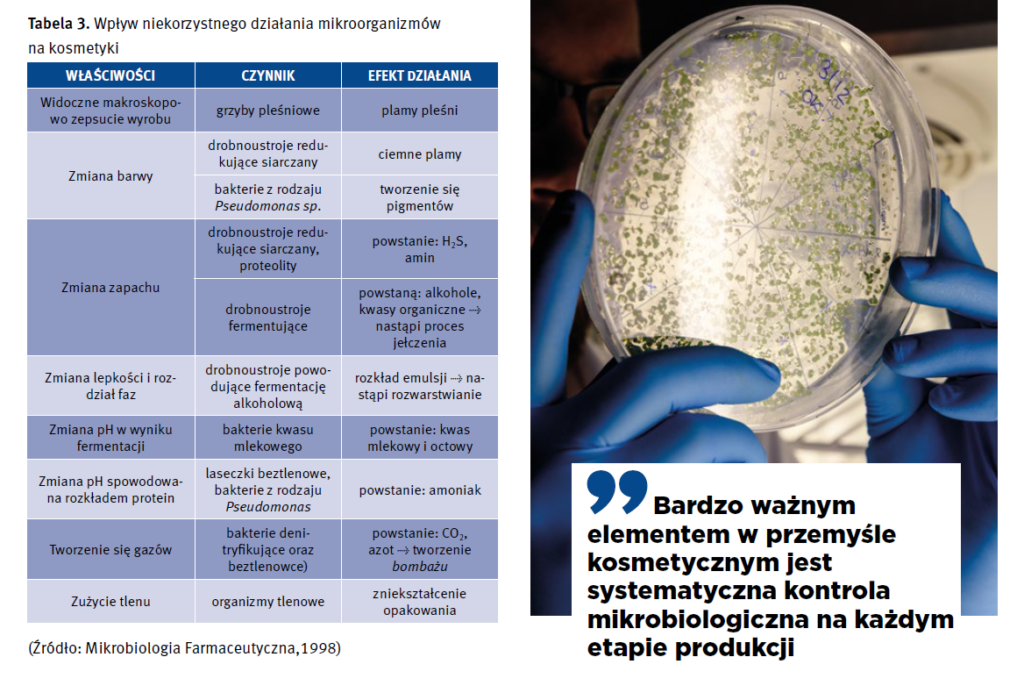

Jakość i bezpieczeństwo
ZANIECZYSZCZENIA MIKROBIOLOGICZNE W KOSMETYKACH – JAK IM ZAPOBIEGAĆ I JAK JE SKUTECZNIE WYKRYWAĆ?
Podstawowym celem produkcji kosmetyków jest opracowanie receptury bezpiecznego produktu dla użytkowników oraz spełniającego określone normy jakości, w szczególności wymagania mikrobiologiczne. Aby uzyskać produkt wysokiej jakości, wolny od niepożądanych mikroorganizmów, konieczne jest przestrzeganie rygorystycznych standardów Dobrej Praktyki Produkcyjnej (GMP) oraz Dobrej Praktyki Higienicznej (GHP) w procesach produkcji, ze szczególnym uwzględnieniem skutecznego systemu zarządzania jakością mikrobiologiczną. Wysokie ryzyko zakażenia produktów w przemyśle kosmetycznym, które może wystąpić na każdym etapie cyklu produkcyjnego lub w trakcie użytkowania przez konsumenta, sprawia, że przeprowadzanie analiz mikrobiologicznych – zwłaszcza oceny poziomu zanieczyszczenia drobnoustrojami jest konieczne.
Zgodnie z Rozporządzeniem (WE) 1223/2009 z dnia 30 listopada 2009 r. dotyczącym produktów kosmetycznych, każdy produkt wprowadzany do obrotu i używany w dedykowanych warunkach użytkowania nie może stanowić zagrożenia dla zdrowia ludzi. Dokument ten zobowiązuje producentów do posiadania pełnej dokumentacji wdrożeniowej, w której zawarte są badania potwierdzające bezpieczeństwo danego produktu dla zdrowia konsumentów.
Na podstawie Rozporządzenia WE 1223/2009 i zawartym w nim artykułem 8, kluczowym dowodem bezpieczeństwa produktu jest wprowadzenie zasad GMP w oparciu o rekomendowaną normę, czyli PN EN ISO 22716:2009 Kosmetyki – Dobre Praktyki Produkcji (GMP) – Przewodnik Dobrych Praktyk Produkcji. Jest to jednoznaczne z posiadaniem dedykowanych procedur i zapisów, dokumentujących wdrożenie i funkcjonowanie systemu zapewnienia jakości mikrobiologicznej w całym toku produkcyjnym. System ten powinien obejmować kontrolę na każdym etapie procesu tj. od momentu pozyskania surowców i opakowań, przez cały proces produkcyjny, aż po końcowy wyrób gotowy przygotowany do wysyłki i dystrybucji. Warto podkreślić, że zgodnie z obowiązującymi przepisami prawa, producent czy dystrybutor są odpowiedzialni za cały łańcuch „życia” produktu do momentu zakończenia użytkowania danego produktu przez konsumenta.
Ocenę czystości mikrobiologicznej kosmetyków na terenie Unii Europejskiej przeprowadza się według wytycznych ujętych w (WE) 1223/2009 ze wskazaniem na normę PN EN ISO 17516:2014-11 Kosmetyki – Mikrobiologia – Limity mikrobiologiczne. Dokument ten wskazuje odniesienia do wymagań dotyczących czystości mikrobiologicznej (kryteria badania ilościowego i jakościowego – tabela nr 2), w których to można znaleźć dedykowane metody badawcze w oparciu o międzynarodowe standardy ISO (tabela nr 1):

W tabeli nr 2 przedstawiono zalecane wymagania czystości mikrobiologicznej dla wyrobów kosmetycznych zgodne PN EN ISO 17516:2014-11.
Zgodnie z powyższymi wymaganiami, kosmetyki powinny być „wolne” od drobnoustrojów potencjalnie chorobotwórczych tj.: Escherichia coli, Staphylococcus aureus, Pseudomonas aeruginosa oraz Candida albicans. Maksymalne dopuszczalne ilości tlenowych drobnoustrojów mezofilnych dla kosmetyków przeznaczonych dla dzieci i w okolice oczu lub błoń śluzowych (dawna kategoria I) wynoszą 200 jtk/g. Dla pozostałych kosmetyków (kategoria II) znacznie więcej, bo wskazanie jest aż do 2000 jtk/g produktu. Co raz częściej, ze względu na specyfikę produkcji bądź też rodzaju, matrycy wyrobu gotowego, wprowadzane są badania dodatkowe rozszerzone o wskaźniki mikrobiologiczne jakościowe tzn. obecności drobnoustrojów będących potencjalnym zagrożeniem dla konsumenta np. Burkholderia cepacia, Pluralibacter gergoviae (d. Enterobacter gergoviae), Salmonella sp., Clostridium perfringens, Serratia marcescens czy też Klebsiella pneumoniae. Są to patogeny szczególnie niebezpieczne, które mogą powodować zagrażające życiu infekcje u osób z uszkodzeniami skóry i przewlekle chorych oraz pacjentów po zabiegach operacyjnych z obniżoną odpornością.
W cyklu tzw. „życia” kosmetyku można wyróżnić dwa główne źródła skażenia mikrobiologicznego produktu:
- skażenie mikrobiologiczne związane z produkcją, czyli tzw. skażenie pierwotne,
- skażenie mikrobiologiczne związane ze stosowaniem kosmetyku, czyli tzw. skażenie wtórne.
Potencjalne ryzyko pierwotnego zakażenia mikrobiologicznego pojawia się już na etapie przyjęcia surowców do zakładu, obejmując ich przetwarzanie w produkt końcowy, pakowanie oraz dalszą dystrybucję. W szczególności największe ryzyko stanowią surowce pochodzenia naturalnego (tj. mineralne i roślinne). Ogromny wpływ na ich czystość mikrobiologiczną mają warunki, sposób ich pozyskiwania, przechowywania, transportu czy też dalszego przetwarzania do produktu końcowego. Surowce te są najczęściej zanieczyszczone mikroflorą pochodzącą z gleby, powietrza, wody czy też innych źródeł potencjalnie zawierających żywe mikroorganizmy. Większość surowców charakteryzuje się różnorodną mikroflorą towarzyszącą, która może ulec namnożeniu podczas transportu, przechowywania czy nawet niewłaściwego suszenia. Szczególnie niebezpieczne są zarodniki grzybów pleśniowych zawierające szeroką gamę niebezpiecznych toksyn. Należy również pamiętać, że morfologiczne formy bakterii tj. laseczki tlenowe i beztlenowe, potrafią przetrwać w wysokich temperaturach. Dzięki charakterystycznym formom przetrwalnikowym są one w stanie przeżyć nawet w najbardziej niesprzyjających warunkach środowiskowych, co zapewnia im odporność na różnego rodzaju czynniki zewnętrzne np. niska i wysoka temperatura, brak tlenu czy też znikoma zwartość wody.
Podstawowym składnikiem stosowanym podczas wytwarzania kosmetyków jest woda, która stanowi źródło skażeń różnego rodzaju drobnoustrojami chorobotwórczymi. Woda jest nie tylko składnikiem stosowanym w kolejnych etapach produkcji, ale jest przede wszystkim podstawowym medium, w którym rozpuszczane są poszczególne komponenty receptury. Dodatkowo bierze ona udział w procesach higienicznych (GHP) związanych z myciem i utrzymaniem czystości infrastruktury produkcyjnej. Najczęściej woda jest przyczyną wprowadzenia do produkcji mikroflory chorobotwórczej, w tym głównie bakterii z gatunku Pseudomonas aeruginosa oraz drobnoustrojów z rodziny Enterobacteriaceae, w szczególności bakterii z grupy coli. Stąd też podstawowym warunkiem stosowania wody w produkcji, jest jej systematyczne monitorowanie w różnych punktach cyklu produkcyjnego oraz rygorystyczne przestrzeganie wewnętrznych wymagań jakościowych pod kątem mikrobiologicznym i fizykochemicznym.
Kolejnym ważnym elementem związanym z potencjalnym źródłem zanieczyszczenia mikrobiologicznego jest stan higieniczny całego środowiska produkcyjnego i obszaru przylegającego do niego, czyli środowiska okołoprodukcyjnego. Kluczowy wpływ na jakość produktu ma cała infrastruktura produkcyjna np. maszyny produkcyjne, urządzenia a także czystość powietrza w pomieszczeniach wytwórczych. Drobnoustroje gromadzą się w rozmaitych szczelinach i zakamarkach urządzeń, na powierzchniach tworząc tym samym wielokomórkowe struktury nazywane biofilmem. To właśnie biofilm jest szczególnie niebezpieczny w całym procesie technologicznym i jednocześnie jest on bardzo trudny do zidentyfikowania i usunięcia. Dlatego też właściwe dobrane częstotliwości mycia i skrupulatne przestrzeganie harmonogramów oraz stosowanie odpowiedniej metody dezynfekcji infrastruktury przemysłowej w tym urządzeń produkcyjnych daje możliwość wyeliminowania ryzyka zanieczyszczenia mikrobiologicznego.
Personel produkcyjny stanowi także wysokie ryzyko zakażeń podczas produkcji kosmetyków. Człowiek jest nosicielem ogromnej ilości mikroorganizmów, które stanowią bardzo bogatą i różnorodną mikroflorę. Wśród mikroorganizmów przenoszonych głównie na skórze przez ludzi dominują przede wszystkim mikroorganizmy patogenne, które stanowią główne zagrożenie podczas procesu produkcji kosmetyków. Podstawowe znaczenie dla zachowania higieny produkcji mają bakterie z rodziny Enterobacteriaceae oraz gronkowce koagulazo – dodatnie, które są głównymi sprawcami zakażeń produktów wywołanych przez personel.
Jednym ze wskaźników wymagającym ciągłego monitorowania w zakładzie produkcyjnym jest stopień zanieczyszczenia mikrobiologicznego powietrza. Wynika to z faktu, że nawet chwilowy kontakt otwartego produktu z zanieczyszczonym powietrzem może pozostawić na jego powierzchni kolonie bakterii lub zarodniki pleśni, powodujące „psucie się” wyrobu. W efekcie końcowym, produkt może być zdyskwalifikowany pod względem jakościowym. Warto dodać, że nie ma dedykowanych wymogów czystości powietrza dla branży kosmetycznej. Najczęściej kryteria te zakłady przemysłowe ustalają indywidualnie, przeprowadzając proces wnikliwej walidacji i tym samym wskazując swoje wewnętrzne limity ostrzegawcze i krytyczne.
Kolejne nowe źródła zakażenia kosmetyków pojawiają się z chwilą otwarcia jego opakowania (tzw. zakażenie wtórne), czyli zanieczyszczenie pojawiajcie się poprzez użytkowanie produktu gotowego przez konsumenta. Produkt narażony jest wtedy na nowe źródła potencjalnego zakażenia mikroorganizmami chorobotwórczymi znajdującymi się w otaczającym środowisku. Stopień skażenia produktu związany jest przede wszystkim z warunkami przechowywania oraz sposobem i higieną stosowania kosmetyku przez konsumenta.
Aby zabezpieczyć kosmetyki przed zakażeniem podczas użytkowania, stosuje się odpowiednie dobrane układy konserwantów oraz dobiera się opakowania, które zapobiegają bezpośredniemu kontaktowi kosmetyku ze środowiskiem zewnętrznym, tj. dozowniki typu airless, dozowniki z pompką, czy opakowania aerozolowe.
Dlatego bardzo ważnym elementem w przemyśle kosmetycznym jest systematyczna kontrola mikrobiologiczna produktów na każdym etapie produkcji. Badania mikrobiologiczne pozwalają określić miejsca najwyższego ryzyka zakażeń produktów podczas produkcji i tym samym utrzymać rygor jakości wytwarzanych kosmetyków. Źródła skażeń mikrobiologicznych w przemyśle mogą znajdować się w surowcach, w środowisku produkcyjnym, jak również mogą wynikać z bezpośredniego kontaktu gotowego produktu z drobnoustrojami podczas użytkowania. Skażenie kosmetyków może prowadzić do poważnych i niebezpiecznych konsekwencji nie tylko dla zdrowia konsumenta, ale również dla procesów technologicznych powodując widoczne zmiany w strukturze i jakości gotowego wyrobu (Tabela nr 3 i 4). Dlatego też w interesie każdego producenta jest zminimalizowanie potencjalnych źródeł zakażenia, w którym produkt może ulec kontaminacji mikrobiologicznej.

Badania mikrobiologiczne kosmetyków odgrywaj kluczową role w zapewnieniu bezpieczeństwa i jakości produktów kosmetycznych. System kontroli mikrobiologicznej wymienionych powyżej potencjalnych źródeł stanowi zasadniczy warunek zapewnienia wymaganej jakości produktów końcowych. Jednak sposób doboru dopuszczalnych kryteriów akceptacji limitów mikrobiologicznych jest sprawą indywidualną producenta i zależy głównie od ogólnego stanu higieniczno sanitarnego zakładu. Kluczowymi elementami wpływającymi ma czystość mikrobiologiczną są także odpowiednio dobrane procedury dezynfekcji, właściwe konstrukcje maszyn produkcyjnych oraz rzetelne stosowanie przez pracowników zasad Dobrej Higieny Produkcyjnej (GHP). Tym samym przestrzeganie zasad Dobrej Praktyki Produkcyjnej (GMP) w zakresie czystości mikrobiologicznej ułatwia utrzymanie na wysokim poziomie jakości produktu końcowego w przemyśle.
Bibliografia
1. Parnowska W. Mikrobiologia Farmaceutyczna, PZWL 1998.
2. Rozporządzenie Parlamentu Europejskiego i Rady (WE) nr 1223/2009 z dnia 30 listopada 2009 r. dotyczące produktów kosmetycznych.
3. Kayser F., Bienz K., Eckert J., Zinkernagel R. Medical Microbiology, Thieme, 2004.
4. Praca zbiorowa pod red. Kobiela T. Laboratorium badania surowców i form kosmetycznych, PW, 2022.
5. Siegert W., Evaluation of the microbiological safety of finished cosmetic products, Euro Cosmetics, 2010.
6. Skowron K., Jakubicz A., Budzyńska A. i wsp. Microbiological purity assessment of cosmetics used by one and several persons and cosmetics after their expiry date. Rocz Państw. Zakł. Hig. 2017; 68(2).
7. Nowaczyk P., Korzekwa K. Atlas mikrobiologii kosmetyków, Poligraf, 2017.
8. Herrera A.G. Microbiological analysis of cosmetics. Methods Mol Biol 2004, 268, 293–295.
9. PN-EN ISO 17516: 2014-11 Kosmetyki – Mikrobiologia – Limity mikrobiologiczne.
10. PN-EN ISO 29621:2017-04 Kosmetyki – Mikrobiologia – Wytyczne dotyczące oceny ryzyka i identyfikacji produktów o niskim ryzyku mikrobiologicznym.
11. PN EN ISO 21148:2017-07 Kosmetyki – Mikrobiologia – Ogólne wytyczne badań mikrobiologicznych.
12. PN EN ISO 16212:2017-08/A1:2023-01 Kosmetyki – Mikrobiologia – Oznaczanie liczby drożdży i pleśń.
13. PN EN ISO 21149:2017-07; /A1:2023-01 Kosmetyki – Mikrobiologia – Zliczanie i wykrywanie mezofilnych bakterii tlenowych.
14. PN EN ISO 21150:2016-01/A1:2023-03 Kosmetyki – Mikrobiologia – Wykrywanie obecności Escherichia coli.
15. PN EN ISO 22717:2016-01/A1:2023-03 Kosmetyki – Mikrobiologia – Wykrywanie obecności Pseudomonas aeruginosa.
16. PN EN ISO 22718:2016-01/A1:2023-01 Kosmetyki – Mikrobiologia – Wykrywanie obecności Staphylococcus aureus.
17. PN EN ISO 18416:2016-01/A1:2023-03 Kosmetyki – Mikrobiologia – Wykrywanie obecności Candida albicans.
18. PN EN ISO 18415:2017-07.A1:2023-02 Kosmetyki – Mikrobiologia – Wykrywanie mikroorganizmów specyficznych i niespecyficznych.
19. PN-EN ISO 22716:2009 – Kosmetyki – Dobre Praktyki Produkcji (GMP) – Przewodnik Dobrych Praktyk Produkcji.
Dodatkowe informacje
Artykuł został opublikowany w kwartalniku „Świat Przemysłu Kosmetycznego” 4/2025
Zobacz także
- Badania kosmetyków z udziałem ludzi – od wymogów regulacyjnych po praktykę laboratoryjną. Dlaczego badania na ludziach wciąż są kluczowe, mimo rozwoju technologii in vitro i AI?
- Pomiar barwy i fluorescencji – jak kontrolować oba zjawiska jednocześnie?
- Składniki aktywne – kiedy warto zaufać deklaracjom dostawcy, a kiedy badać samodzielnie?

